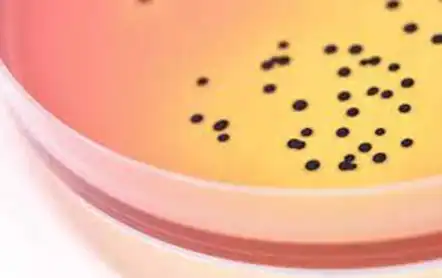
Neogen One Plate

NEOGEN® Kültür Besiyerleri: Teknik Mükemmeliyet ve Kalite Standartları
35 yılı aşkın sektör deneyimine sahip olan NEOGEN®, mikrobiyoloji ürün gamını geliştirme ve genişletme amacıyla sürekli olarak Ar-Ge yatırımları yapmaktadır. Farklı laboratuvar ihtiyaçlarına uygun çeşitli formatlarda yüksek kaliteli kültür besiyerleri ve tamamlayıcı mikrobiyolojik test çözümleri üretmektedir.
Ürün yelpazesi şunları içermektedir:
- Dehidre kültür besiyerleri (DCM)
- Besiyeri katkıları
- İmmünomanyetik seperasyon (IMS)
Kalite Güvencesi ve Sertifikasyon
Kültür besiyeri üretim sürecinde:
- Sadece onaylı tedarikçilerden temin edilen yüksek kaliteli hammaddeler kullanılmaktadır.
- İleri düzey üretim ekipmanları ile üretim gerçekleştirilmekte,
- Süreç boyunca kalite ve performans kontrolleri, deneyimli teknik ekiplerce sağlanmaktadır.
Bu kalite yönetimi uygulamaları, mikrobiyolojik analizlerde güvenilir, doğru ve tekrarlanabilir sonuçlar elde edilmesini mümkün kılmaktadır.
Uluslararası Standartlara Uygunluk
- İngiltere ve ABD’deki üretim tesisleri ISO 9001:2015 kalite yönetim sistemi standardına uygundur.
- İngiltere üretim tesisi ayrıca ISO 13485:2016 standardı kapsamında kültür besiyerlerinin tasarımı, üretimi ve tedariki için sertifikalıdır.